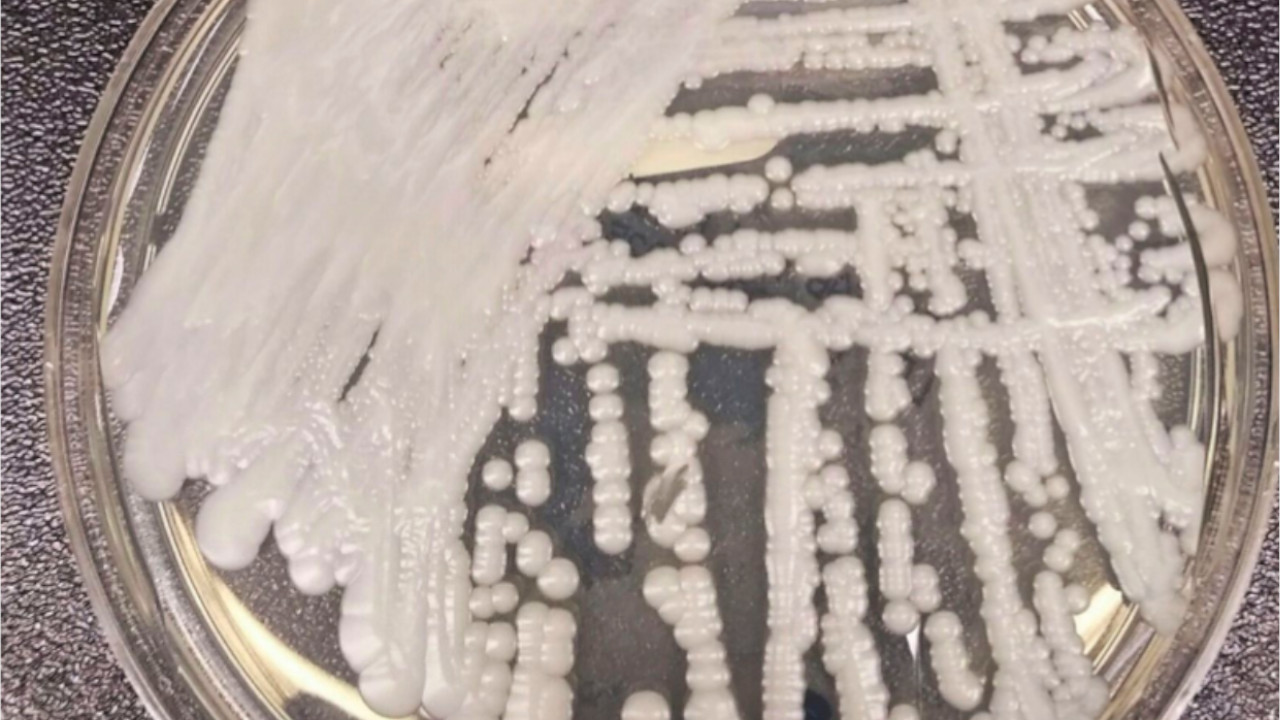

Un hongo llamado ‘Candida auris’, se expande por los Estados Unidos. Este es un microorganismo potencialmente mortal bastante resistente a los medicamentos y tratamientos comunes.
Los investigadores estadounidenses están preocupados, ya que el hongo se propagó “a un ritmo alarmante” de 2019 a 2021, según información recientemente difundida por los CDC.
Desde el año 2021 se han informado de 1.474 casos clínicos, lo que indica un aumento del 200% con respecto a los casi 500 casos de 2019.
La OMS, catalogó al ‘Candida auris’ como una “amenaza urgente”, ya que el hongo se propaga fácilmente a través de los centros de atención médica y puede causar una enfermedad mortal.
Según la revista especializada Annals of Internal Medicine, el hongo ‘Candida auris’ ya está presente en más de 50 estados norteamericanos. Incluso, de acuerdo con las autoridades sanitarias, este virus es bastante resistente a las equinocandinas, el principal fármaco que se utiliza para tratar infecciones.
Más noticias Internacionales

Comunicadora Social con énfasis en Transmedia, apasionada por conectar audiencias a través de historias, estratégias y multiformato.
- Compartir:
- Compartir en Facebook
- Compartir en X (Twitter)
- Compartir en WhatsApp
- Comentarios

